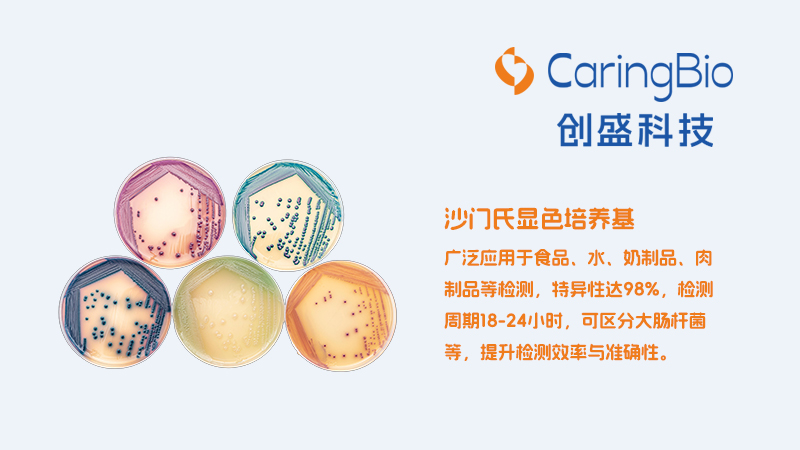
产品二.jpg
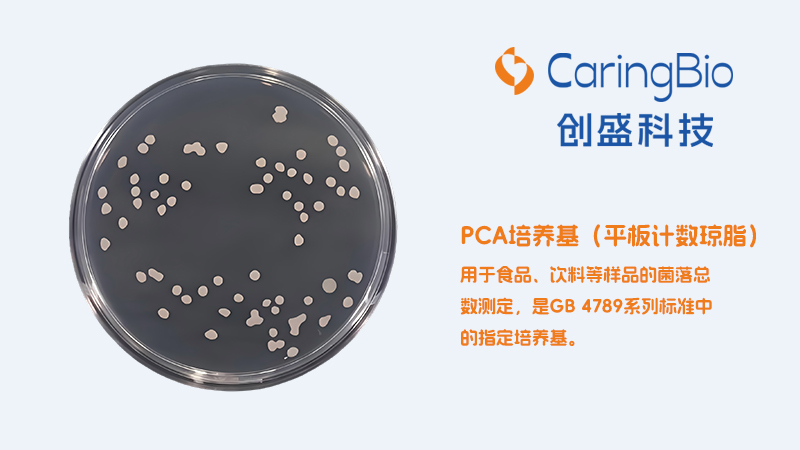
产品五.jpg

作为食品安全技术领域规模最大、人气最旺和最受欢迎的行业盛会之一,CBIFS第十八届食品安全技术论坛暨太平洋食安展将于2026年4月9日-10日在苏州举办。
江门创盛确认参展本次论坛,欢迎各位领导专家和客户朋友参观交流、合作洽谈!


江门市创盛科技有限公司
江门市创盛科技有限公司成立于2023年,依托江门市凯林贸易有限公司三十年微生物商品化培养基技术积淀,是一家集研发、生产、销售于一体的专业微生物检测试剂企业,致力于提供高质量检测解决方案。同年,公司在江门市木朗大道151号B、C幢建成符合GMP要求的洁净厂房,内含十万级、万级洁净车间及检验区域,检验区配备专业实验室。
生产上,公司按ISO13485标准建立质量管理体系,引进智能化培养基制备系统、全自动包装流水线等先进设备,保障生产规范化。
销售服务以客户为中心,拥有专业团队提供咨询、技术支持与售后服务,注重客户反馈以提升满意度。
公司产品涵盖Ⅱ类6840体外诊断试剂,种类齐全、质量可靠,广泛应用于医疗、卫生、食品、工业等微生物领域。未来将秉承“质量第一、客户至上”原则,持续提供优质产品与服务。
电话:0750-3227833
地址:广东省江门市蓬江区木朗大道151号
网址:https://www.bio-caring.cn/

- 扫码关注公众号 -

匀质袋装培养基
匀质袋装培养基核心优势是高度集成化与即用型设计。使用时加入样品与无菌水,在拍击式均质器内同步完成培养基复水、样品均质化和微生物增菌,简化流程,节省时间。而且,预灭菌包装与标准化配方降低污染风险和人为误差,提升检测结果可靠性与一致性。
食品样品微生物检测
沙门氏菌显色培养基
沙门氏菌显色培养基是食品安全检测专用工具,通过菌落颜色变化快速鉴别沙门氏菌。其原理是沙门氏菌特有酶水解显色底物释放显色基团,使菌落呈紫色或亮红色。该培养基广泛应用于食品、水、奶制品、肉制品等检测,特异性达98%,检测周期18-24小时,可区分大肠杆菌等,提升检测效率与准确性。
食品、水、奶制品、肉制品等沙门氏检测

TSA物表培养基
TSA物表培养基(胰酪大豆胨琼脂培养基)在食品安全领域主要用于各类食品加工环境(如设备表面、工作台面等)的微生物卫生监测。其富含胰酪胨和大豆胨等营养成分,能有效促进物体表面微生物的生长。
食品加工环境检测

菌种保存培养基
食品安全监测中,菌种保存管是长期稳定保藏标准菌株及致病菌的关键工具,可确保其作为后续检测的可靠阳性对照或溯源依据。采用瓷珠吸附与低温保护液结合技术,维持菌种活性与遗传稳定性,保证检测结果准确可比。
食品检测微生物阳性对照
PCA培养基(平板计数琼脂)
主要用于食品、饮料等样品的菌落总数测定,是GB 4789系列标准中的指定培养基。
食品样品总数测定

BP平板培养基(Baird-Parker平板)
培养基中的高浓度氯化钠可抑制多数非目标菌的生长,而亚碲酸钾能被金黄色葡萄球菌还原为黑色的金属碲,使得目标菌落呈现黑色。同时,菌落周围的卵黄成分会被金黄色葡萄球菌产生的酶分解,形成特有的浑浊带和透明环。
选择性分离培养目标菌




